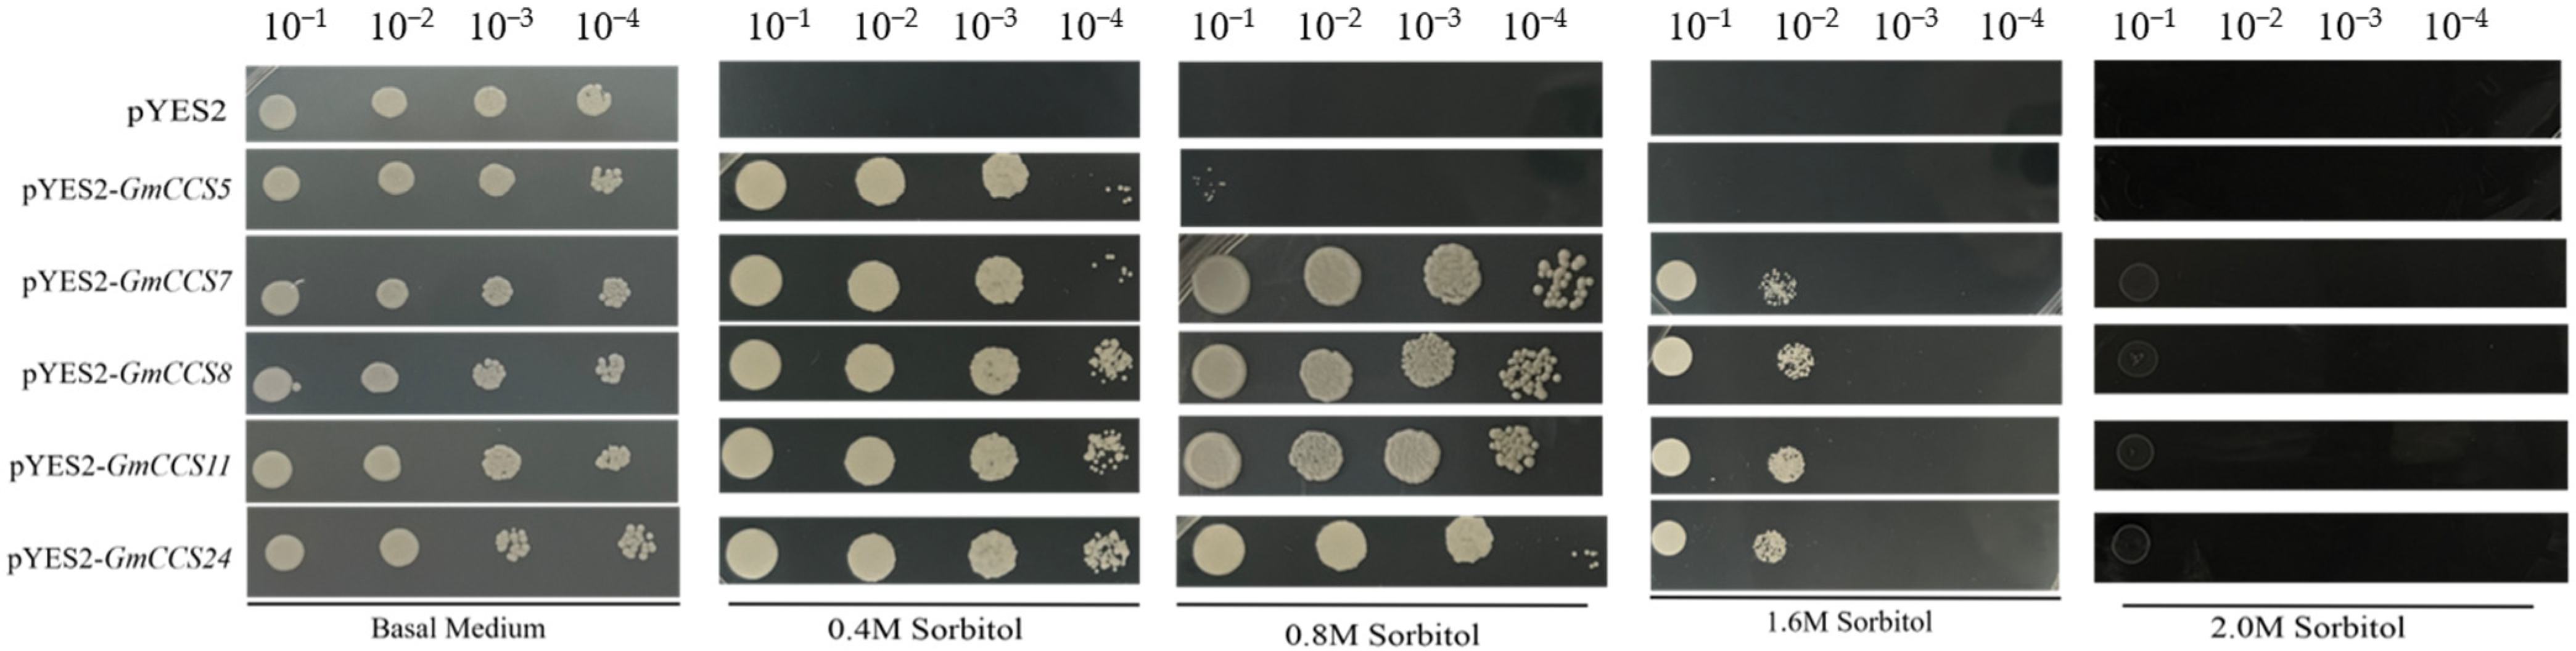

Genome-Wide Identification and Characterization of Copper Chaperone for Superoxide Dismutase (CCS) Gene Family in Response to Abiotic Stress in Soybean
Abstract
1. Introduction
2. Results
2.1. Genome-Wide Identification of the GmCCSs Family of Glycine (G.) Max Subsection
2.2. Gene Structure and Conserved Domain Analysis
2.3. The Motif, Cis-Regulatory Elements and Transcription Factor Analysis of GmCCSs
2.4. Expression Analysis of GmCCS Genes in Different Tissues
2.5. Expression Profiles of the Candidate GmCCS Genes under Different Abiotic Stresses
2.6. Overexpression of Abiotic Candidate GmCCS Genes Improved Drought Tolerance in Yeast Cells
2.7. GmCCS7 and GmCCS24 Improve Drought Stress Tolerance in Transgenic Soybean Hairy Roots
3. Discussion
4. Materials and Methods
4.1. Identification of the GmCCS Gene Family
4.2. Gene Structure, Motif and Conserved Domain Analysis
4.3. Phylogenetic, Cis-Acting Element, Chromosomal Location Analysis, and Interacting Protein Prediction
4.4. Tissue Expression Profiling Analysis of GmCCS Gene Family in Soybean
4.5. Plant Materials and Treatments
4.6. RNA Extraction and RNA Extraction and Reverse Transcription-Quantitative PCR (RT-qPCR) Analysis
4.7. Stress Tolerance Analysis in Yeast
4.8. Stress Tolerance Analysis in Transgenic Soybean Hairy Toots
5. Conclusions
Supplementary Materials
Author Contributions
Funding
Institutional Review Board Statement
Informed Consent Statement
Data Availability Statement
Conflicts of Interest
References
- Minussi Winck, J.E.; Sarmento, L.F.V.; Zanon, A.J.; Librelon, S.S.; Garcia, A.; Streck, N.A. Growth and transpiration of soybean genotypes with HaHB4(R) transcription factor for drought tolerance. Physiol. Plant 2022, 174, e13557. [Google Scholar] [CrossRef] [PubMed]
- Imran, M.; Latif Khan, A.; Shahzad, R.; Aaqil Khan, M.; Bilal, S.; Khan, A.; Kang, S.M.; Lee, I.J. Exogenous melatonin induces drought stress tolerance by promoting plant growth and antioxidant defence system of soybean plants. AoB Plants 2021, 13, plab026. [Google Scholar] [CrossRef] [PubMed]
- Casareno, R.L.; Waggoner, D.; Gitlin, J.D. The copper chaperone CCS directly interacts with copper/zinc superoxide dismutase. J. Biol. Chem. 1998, 273, 23625–23628. [Google Scholar] [CrossRef] [PubMed]
- Rosen, D.R.; Siddique, T.; Patterson, D.; Figlewicz, D.A.; Sapp, P.; Hentati, A.; Donaldson, D.; Goto, J.; O’Regan, J.P.; Deng, H.X.; et al. Mutations in Cu/Zn superoxide dismutase gene are associated with familial amyotrophic lateral sclerosis. Nature 1993, 362, 59–62. [Google Scholar] [CrossRef]
- Furukawa, Y.; Tokuda, E. Does wild-type Cu/Zn-superoxide dismutase have pathogenic roles in amyotrophic lateral sclerosis? Transl. Neurodegener. 2020, 9, 33. [Google Scholar] [CrossRef]
- Kirby, K.; Jensen, L.T.; Binnington, J.; Hilliker, A.J.; Ulloa, J.; Culotta, V.C.; Phillips, J.P. Instability of Superoxide Dismutase 1 of Drosophila in Mutants Deficient for Its Cognate Copper Chaperone. J. Biol. Chem. 2008, 283, 35393–35401. [Google Scholar] [CrossRef]
- Sagasti, S.; Bernal, M.A.; Sancho, D.; Del Castillo, M.B.; Picorel, R. Regulation of the chloroplastic copper chaperone (CCS) and cuprozinc superoxide dismutase (CSD2) by alternative splicing and copper excess in Glycine max. Funct. Plant Biol. 2014, 41, 144–155. [Google Scholar] [CrossRef]
- Fukuoka, M.; Tokuda, E.; Nakagome, K.; Wu, Z.; Nagano, I.; Furukawa, Y. An essential role of N-terminal domain of copper chaperone in the enzymatic activation of Cu/Zn-superoxide dismutase. J. Inorg. Biochem. 2017, 175, 208–216. [Google Scholar] [CrossRef]
- Grasso, M.; Bond, G.J.; Kim, Y.J.; Boyd, S.; Matson Dzebo, M.; Valenzuela, S.; Tsang, T.; Schibrowsky, N.A.; Alwan, K.B.; Blackburn, N.J.; et al. The copper chaperone CCS facilitates copper binding to MEK1/2 to promote kinase activation. J. Biol. Chem. 2021, 297, 101314. [Google Scholar] [CrossRef]
- Benson, D.M., Jr.; Yu, J.; Becknell, B.; Wei, M.; Freud, A.G.; Ferketich, A.K.; Trotta, R.; Perrotti, D.; Briesewitz, R.; Caligiuri, M.A. Stem cell factor and interleukin-2/15 combine to enhance MAPK-mediated proliferation of human natural killer cells. Blood 2009, 113, 2706–2714. [Google Scholar] [CrossRef]
- Boyd, S.D.; Calvo, J.S.; Liu, L.; Ullrich, M.S.; Skopp, A.; Meloni, G.; Winkler, D.D. The yeast copper chaperone for copper-zinc superoxide dismutase (CCS1) is a multifunctional chaperone promoting all levels of SOD1 maturation. J. Biol. Chem. 2019, 294, 1956–1966. [Google Scholar] [CrossRef] [PubMed]
- Maidment, J.H.R.; Franceschetti, M.; Maqbool, A.; Saitoh, H.; Jantasuriyarat, C.; Kamoun, S.; Terauchi, R.; Banfield, M.J. Multiple variants of the fungal effector AVR-Pik bind the HMA domain of the rice protein OsHIPP19, providing a foundation to engineer plant defense. J. Biol. Chem. 2021, 296, 100371. [Google Scholar] [CrossRef]
- Cheng, Y.; Cheng, L.; Hu, G.; Guo, X.; Lan, Y. Auxin and CmAP1 regulate the reproductive development of axillary buds in Chinese chestnut (Castanea mollissima). Plant Cell Rep. 2022, 1–10. [Google Scholar] [CrossRef] [PubMed]
- Yamaguchi-Shinozaki, K.; Shinozaki, K. Organization of cis-acting regulatory elements in osmotic- and cold-stress-responsive promoters. Trends Plant Sci. 2005, 10, 88–94. [Google Scholar] [CrossRef] [PubMed]
- Soma, F.; Takahashi, F.; Yamaguchi-Shinozaki, K.; Shinozaki, K. Cellular Phosphorylation Signaling and Gene Expression in Drought Stress Responses: ABA-Dependent and ABA-Independent Regulatory Systems. Plants 2021, 10, 756. [Google Scholar] [CrossRef]
- Wang, Y.; Zhang, J.; Hu, Z.; Guo, X.; Tian, S.; Chen, G. Genome-Wide Analysis of the MADS-Box Transcription Factor Family in Solanum lycopersicum. Int. J. Mol. Sci. 2019, 20, 2961. [Google Scholar] [CrossRef]
- Li, H.; Li, Y.; Zhang, X.; Cai, K.; Li, Y.; Wang, Q.; Qu, G.; Han, R.; Zhao, X. Genome-wide identification and expression analysis of the MADS-box gene family during female and male flower development in Juglans mandshurica. Front. Plant Sci. 2022, 13, 1020706. [Google Scholar] [CrossRef]
- Zhao, J.; Gong, P.; Liu, H.; Zhang, M.; He, C. Multiple and integrated functions of floral C-class MADS-box genes in flower and fruit development of Physalis floridana. Plant Mol. Biol. 2021, 107, 101–116. [Google Scholar] [CrossRef]
- Ruta, V.; Longo, C.; Lepri, A.; De Angelis, V.; Occhigrossi, S.; Costantino, P.; Vittorioso, P. The DOF Transcription Factors in Seed and Seedling Development. Plants 2020, 9, 218. [Google Scholar] [CrossRef]
- Cheng, Z.; Hou, D.; Liu, J.; Li, X.; Xie, L.; Ma, Y.; Gao, J. Characterization of moso bamboo (Phyllostachys edulis) Dof transcription factors in floral development and abiotic stress responses. Genome 2018, 61, 151–156. [Google Scholar] [CrossRef]
- Li, L.; Shi, Q.; Li, Z.; Gao, J. Genome-wide identification and functional characterization of the PheE2F/DP gene family in Moso bamboo. BMC Plant Biol. 2021, 21, 158. [Google Scholar] [CrossRef] [PubMed]
- Wang, H.; Zhang, Y.; Norris, A.; Jiang, C.Z. S1-bZIP Transcription Factors Play Important Roles in the Regulation of Fruit Quality and Stress Response. Front. Plant Sci. 2021, 12, 802802. [Google Scholar] [CrossRef] [PubMed]
- Zhao, P.; Hou, S.; Guo, X.; Jia, J.; Yang, W.; Liu, Z.; Chen, S.; Li, X.; Qi, D.; Liu, G.; et al. A MYB-related transcription factor from sheepgrass, LcMYB2, promotes seed germination and root growth under drought stress. BMC Plant Biol. 2019, 19, 564. [Google Scholar] [CrossRef] [PubMed]
- Himelblau, E.; Mira, H.; Lin, S.J.; Culotta, V.C.; Penarrubia, L.; Amasino, R.M. Identification of a functional homolog of the yeast copper homeostasis gene ATX1 from Arabidopsis. Plant Physiol. 1998, 117, 1227–1234. [Google Scholar] [CrossRef]
- Wong, P.C.; Waggoner, D.; Subramaniam, J.R. Copper chaperone for superoxide dismutase is essential to activate mammalian Cu/Zn superoxide dismutase. Proc. Natl. Acad. Sci. USA 2000, 97, 2886–2891. [Google Scholar] [CrossRef]
- Chu, C.C.; Lee, W.C.; Guo, W.Y.; Pan, S.M.; Chen, L.J.; Li, H.M.; Jinn, T.L. A copper chaperone for superoxide dismutase that confers three types of copper/zinc superoxide dismutase activity in Arabidopsis. Plant Physiol. 2005, 139, 425–436. [Google Scholar] [CrossRef]
- Feng, X.; Chen, F.; Liu, W.; Thu, M.K.; Zhang, Z.; Chen, Y.; Cheng, C.; Lin, Y.; Wang, T.; Lai, Z. Molecular Characterization of MaCCS, a Novel Copper Chaperone Gene Involved in Abiotic and Hormonal Stress Responses in Musa acuminata cv. Tianbaojiao. Int. J. Mol. Sci. 2016, 17, 441. [Google Scholar] [CrossRef]
- Chen, C.; Chen, H.; Zhang, Y.; Thomas, H.R.; Frank, M.H.; He, Y.; Xia, R. TBtools: An Integrative Toolkit Developed for Interactive Analyses of Big Biological Data. Mol. Plant 2020, 13, 1194–1202. [Google Scholar] [CrossRef]
- Willems, E.; Leyns, L.; Vandesompele, J. Standardization of real-time PCR gene expression data from independent biological replicates. Anal. Biochem. 2008, 379, 127–129. [Google Scholar] [CrossRef]
- Gautam, R.; Ahmed, I.; Shukla, P.; Meena, R.K.; Kirti, P.B. Genome-wide characterization of ALDH Superfamily in Brassica rapa and enhancement of stress tolerance in heterologous hosts by BrALDH7B2 expression. Sci. Rep. 2019, 9, 7012. [Google Scholar] [CrossRef]
- Kereszt, A.; Li, D.; Indrasumunar, A.; Nguyen, C.D.; Nontachaiyapoom, S.; Kinkema, M.; Gresshoff, P.M. Agrobacterium rhizogenes-mediated transformation of soybean to study root biology. Nat. Protoc. 2007, 2, 948–952. [Google Scholar] [CrossRef] [PubMed]
- Shi, W.Y.; Du, Y.T.; Ma, J.; Min, D.H.; Jin, L.G.; Chen, J.; Chen, M.; Zhou, Y.B.; Ma, Y.Z.; Xu, Z.S.; et al. The WRKY Transcription Factor GmWRKY12 Confers Drought and Salt Tolerance in Soybean. Int. J. Mol. Sci. 2018, 19, 4087. [Google Scholar] [CrossRef] [PubMed]
- Ning, P.; Liu, C.; Kang, J.; Lv, J. Genome-wide analysis of WRKY transcription factors in wheat (Triticum aestivum L.) and differential expression under water deficit condition. PeerJ 2017, 5, e3232. [Google Scholar] [CrossRef] [PubMed]

Disclaimer/Publisher’s Note: The statements, opinions and data contained in all publications are solely those of the individual author(s) and contributor(s) and not of MDPI and/or the editor(s). MDPI and/or the editor(s) disclaim responsibility for any injury to people or property resulting from any ideas, methods, instructions or products referred to in the content. |
© 2023 by the authors. Licensee MDPI, Basel, Switzerland. This article is an open access article distributed under the terms and conditions of the Creative Commons Attribution (CC BY) license (https://creativecommons.org/licenses/by/4.0/).
Share and Cite
Jiao, S.; Feng, R.; He, Y.; Cao, F.; Zhao, Y.; Zhou, J.; Zhai, H.; Bai, X. Genome-Wide Identification and Characterization of Copper Chaperone for Superoxide Dismutase (CCS) Gene Family in Response to Abiotic Stress in Soybean. Int. J. Mol. Sci. 2023, 24, 5154. https://doi.org/10.3390/ijms24065154
Jiao S, Feng R, He Y, Cao F, Zhao Y, Zhou J, Zhai H, Bai X. Genome-Wide Identification and Characterization of Copper Chaperone for Superoxide Dismutase (CCS) Gene Family in Response to Abiotic Stress in Soybean. International Journal of Molecular Sciences. 2023; 24(6):5154. https://doi.org/10.3390/ijms24065154
Chicago/Turabian StyleJiao, Shuang, Rui Feng, Yu He, Fengming Cao, Yue Zhao, Jingwen Zhou, Hong Zhai, and Xi Bai. 2023. "Genome-Wide Identification and Characterization of Copper Chaperone for Superoxide Dismutase (CCS) Gene Family in Response to Abiotic Stress in Soybean" International Journal of Molecular Sciences 24, no. 6: 5154. https://doi.org/10.3390/ijms24065154
APA StyleJiao, S., Feng, R., He, Y., Cao, F., Zhao, Y., Zhou, J., Zhai, H., & Bai, X. (2023). Genome-Wide Identification and Characterization of Copper Chaperone for Superoxide Dismutase (CCS) Gene Family in Response to Abiotic Stress in Soybean. International Journal of Molecular Sciences, 24(6), 5154. https://doi.org/10.3390/ijms24065154

